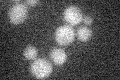
YOR177C
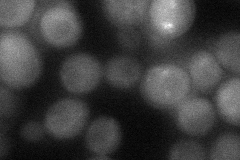
YOR177C

View description
Component of the meiotic outer plaque, a membrane-organizing center which is assembled on the cytoplasmic face of the spindle pole body during meiosis II and triggers the formation of the prospore membrane; potential Cdc28p substrate
Localization:
Intensity:
Fold change:
Significance:
-
C’ GFP library in SD
below threshold16.88 -
N' NOP1pr-GFP in SD

cytosol63.4969 -
N' TEF2pr-mCherry in SD

cytosol71.2408 -
N' NATIVEpr-GFP in SD

below threshold20.6033 -
N' TEF2pr-VC and Cyto-VN in SD
cytosol40.9612 -
C’ GFP library in SD+DTT

cytosol17.061.01No -
C’ GFP library in SD+H2O2

cytosol15.610.92No -
C’ GFP library in Starvation Media

cytosol13.730.81No -
C’ GFP library on the background of Pup2-DaMP

below threshold -
C’ GFP library on the background of CCT mutant

below threshold19.6811.16533No
